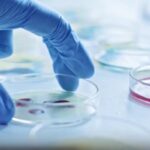

Comprese calde sau reci
Ochii pot fi calmați cu comprese calde sau reci. Puneți o compresă caldă peste ochi. Acest lucru vă va relaxa mușchii și va ameliora oboseala. De asemenea, puteți folosi o lavetă curată și o puteți trece sub apă caldă. Apoi, puneți o compresă rece peste ochi pentru a crește fluxul de sânge pentru a reduce umflăturile și a întări zona ochilor.
Apă de trandafiri
Pentru a vă relaxa ochii, puteți opta și pentru un remediu calmant cu apă de trandafiri. Acest ingredient este eficient împotriva petelor și a cearcănelor. Înmuiați o compresă sau un tampon de vată cu câteva picături de apă de trandafiri. Întindeți-vă, apoi puneți ușor compresa răcoritoare peste ochi și lăsați-o câteva minute. De asemenea, puteți aplica apa de trandafiri direct pe pleoape. Masați ușor înainte de a aplica compresa. Pentru a oferi ochilor strălucirea lor naturală, acest remediu poate fi aplicat de două ori pe zi.
Plicuțele de ceai de mușețel
Puteți folosi, de asemenea, și plicuțele de ceai de mușețel. Proprietățile decongestionante și antiinflamatorii ale ceaiului ajută la strângerea vaselor de sânge, la calmarea pielii și, ca urmare, la reducerea oboselii ochilor. Se pun la infuzat două pliculețe de ceai de mușețel în apă fierbinte. Scoateți pliculețele de ceai și puneți-le în frigider pentru aproximativ douăzeci de minute. Apoi, puneți pliculețele de ceai pe pleoape. Și gata! Relaxați-vă timp de aproximativ zece minute, lăsând ca efectul decongestionant al ceaiului să acționeze asupra pleoapelor dumneavoastră.
Lapte
Laptele are proprietăți utile pentru ameliorarea ochilor obosiți. Cum poate ajuta? Datorită grăsimilor pe care le conține, acest lichid este capabil să liniștească ochii și să calmeze iritațiile. Luați niște vată și înmuiați-o într-un bol cu lapte integral rece, apoi stoarceți-o ușor. Aplicați compresa pe ochi și așteptați 5 minute.
Sursă text: Click.ro